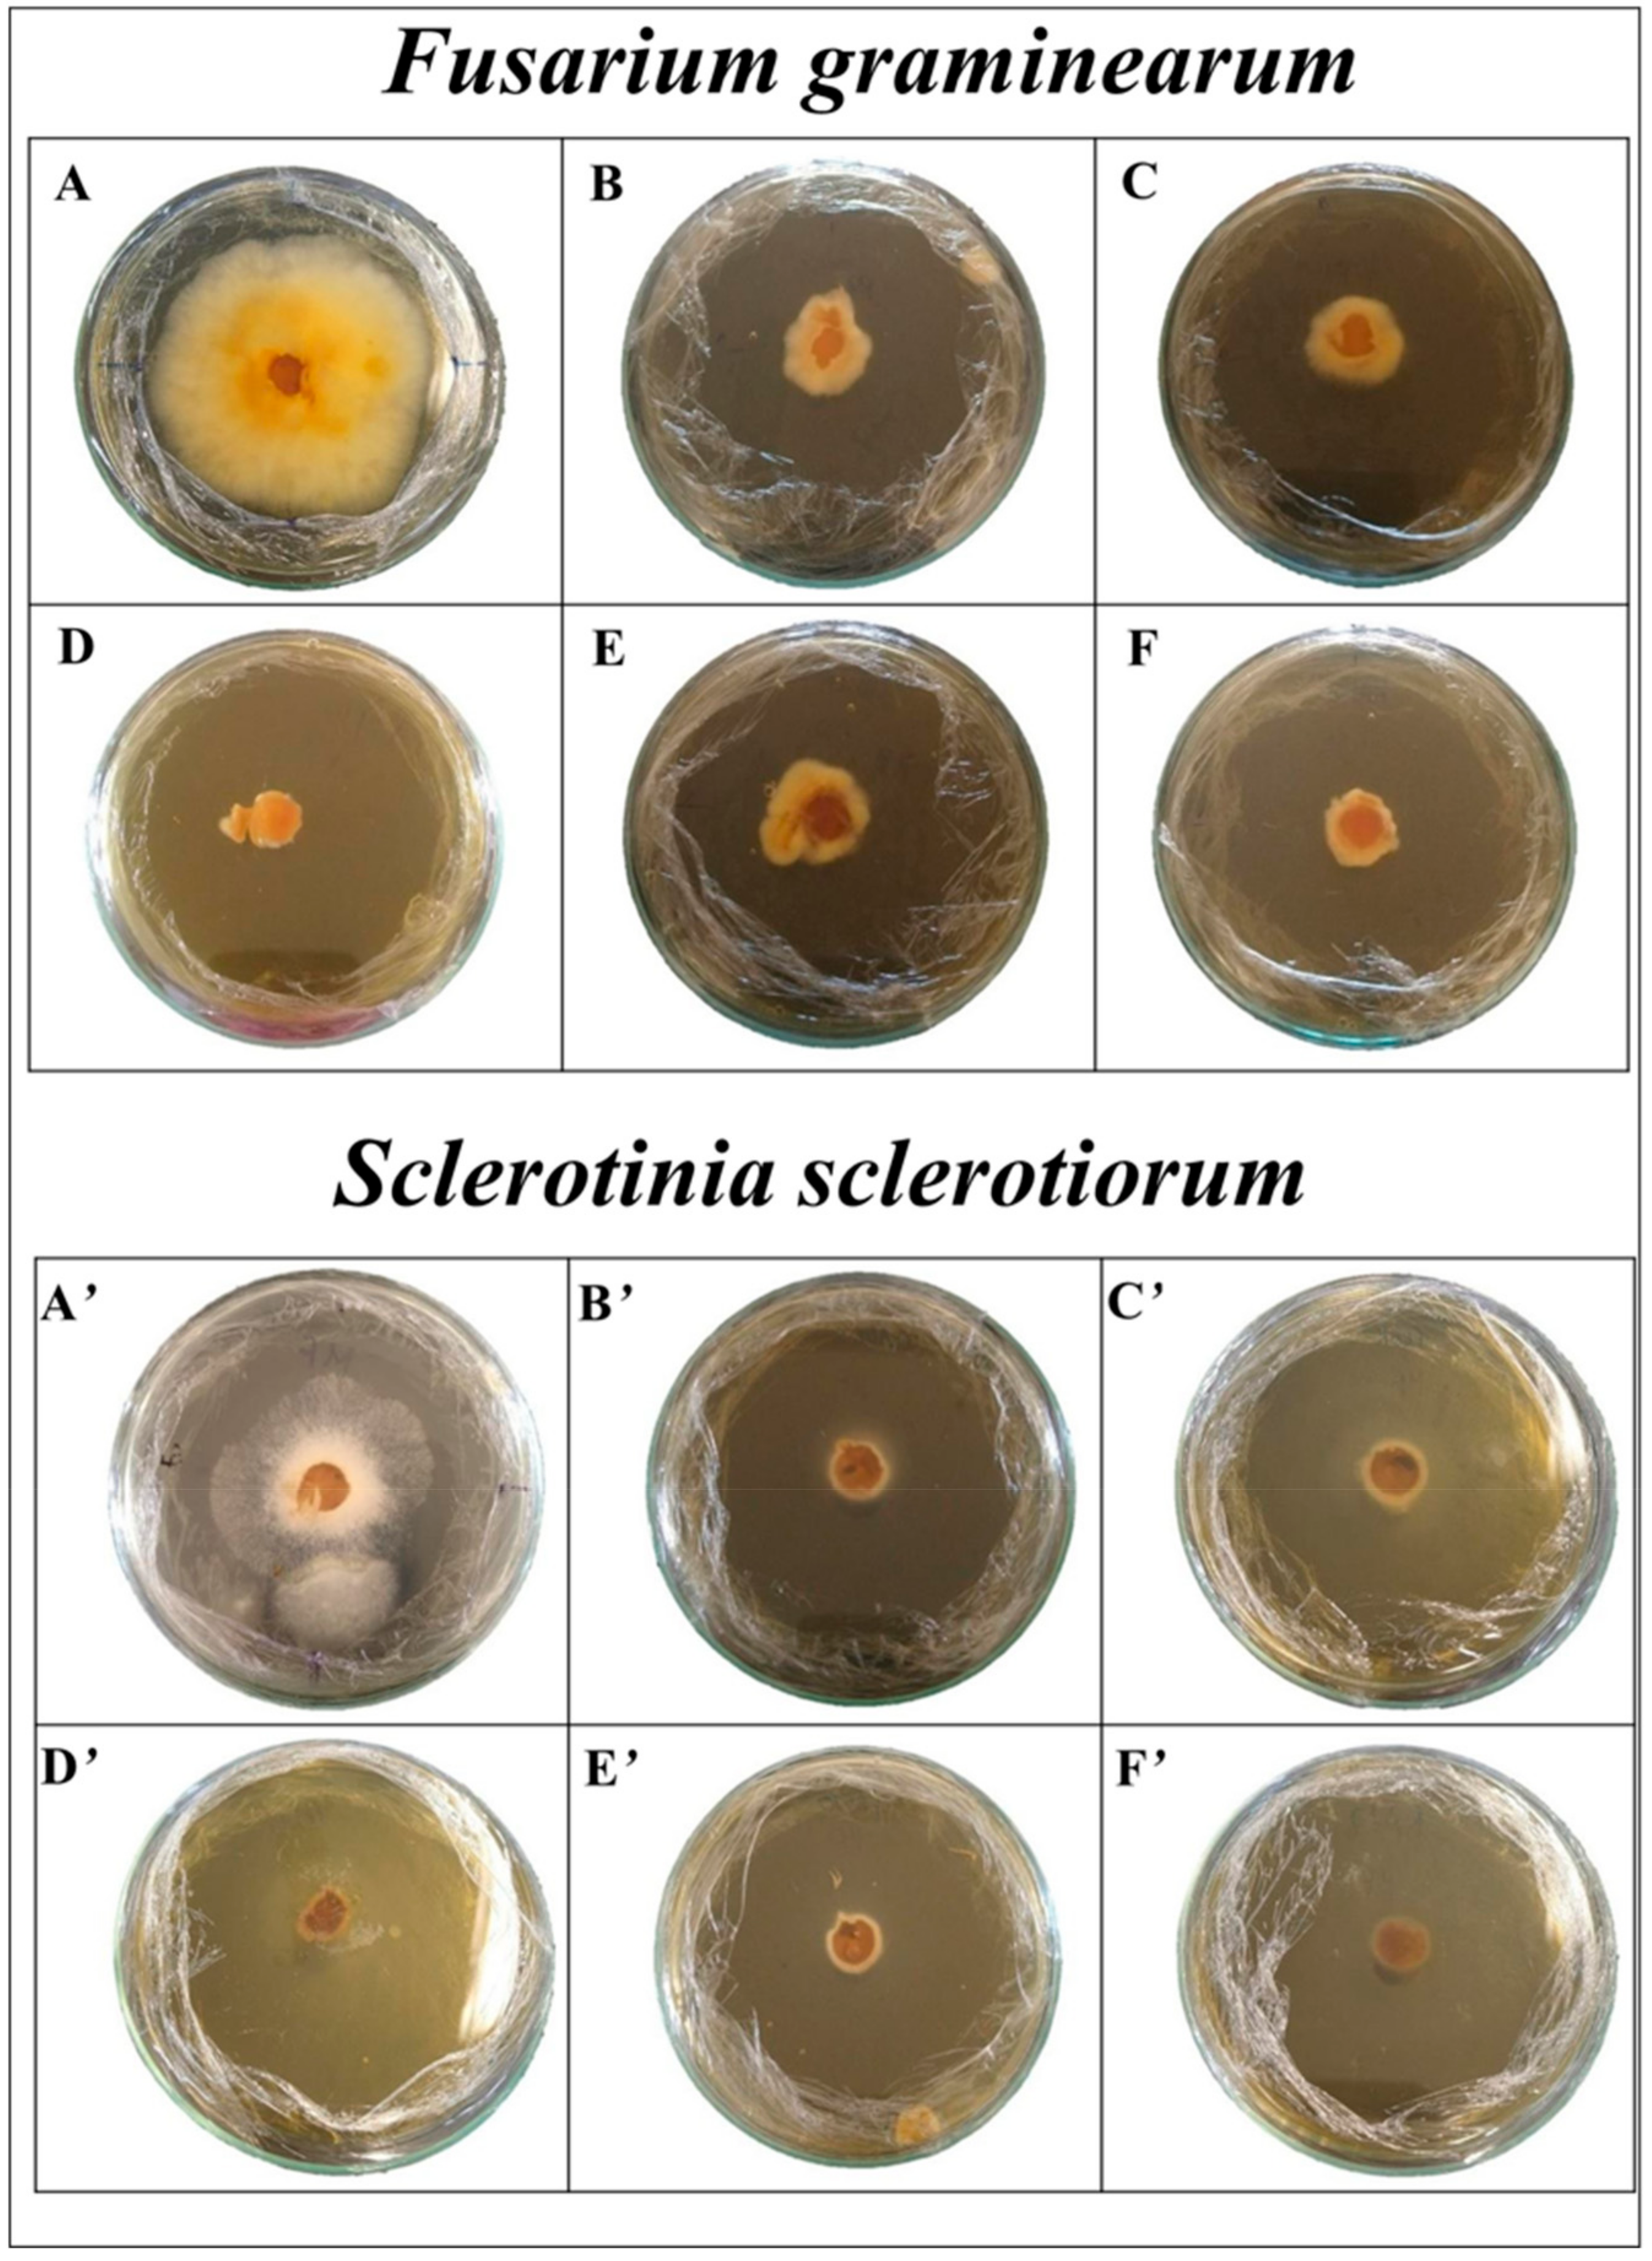
Processes 12 01208 g001

Extracts of Senecio brasiliensis and Solanum viarum as Potential Antifungal and Bioherbicidal Agents
Abstract
1. Introduction
2. Materials and Methods
2.1. Samples
2.2. Extraction Step
2.3. Antifungal Activity
2.4. Analytical Procedure
3. Results and Discussion
3.1. Antifungal Activity
3.2. Herbicidal Activity in Pre-Emergence Tests
4. Conclusions
Author Contributions
Funding
Institutional Review Board Statement
Data Availability Statement
Conflicts of Interest
References
- García, J.A.; Rosas, J.E.; García y Santos, C.; Streitenberger, N.; Feijoo, M.; Dutra, F. Senecio Spp. Transboundary Introduction and Expansion Affecting Cattle in Uruguay: Clinico-Pathological, Epidemiological and Genetic Survey, and Experimental Intoxication with Senecio oxyphyllus. Toxicon 2020, 173, 68–74. [Google Scholar] [CrossRef] [PubMed]
- Winter, E.; Cisilotto, J.; Goetten, A.L.F.; Veiga, Â.; Ramos, A.T.; Zimermann, F.C.; Reck, C.; Creczynski-Pasa, T.B. MicroRNAs as Serum Biomarker for Senecio brasiliensis Poisoning in Cattle. Environ. Toxicol. Pharmacol. 2022, 94, 103906. [Google Scholar] [CrossRef] [PubMed]
- Macedo, G.E.; Gomes, K.K.; Rodrigues, N.R.; Martins, I.K.; Wallau, G.d.L.; Carvalho, N.R.d.; Cruz, L.C.d.; Costa Silva, D.G.d.; Boligon, A.A.; Franco, J.L.; et al. Senecio Brasiliensis Impairs Eclosion Rate and Induces Apoptotic Cell Death in Larvae of Drosophila melanogaster. Comp. Biochem. Physiol. Part C Toxicol. Pharmacol. 2017, 198, 45–57. [Google Scholar] [CrossRef] [PubMed]
- Barcelos, S.T.A.; Dall’Oglio, V.M.; de Araújo, A.; Cerski, C.T.S.; Álvares-da-Silva, M.R. Sinusoidal Obstruction Syndrome Secondary the Intake of Senecio brasiliensis: A Case Report. Ann. Hepatol. 2021, 20, 8–11. [Google Scholar] [CrossRef] [PubMed]
- Panziera, W.; Pavarini, S.P.; Sonne, L.; Barros, C.S.L.; Driemeier, D. Poisoning of Cattle by Senecio spp. In Brazil: A Review. Pesqui. Vet. Bras. 2018, 38, 1459–1470. [Google Scholar] [CrossRef]
- Patel, P.; Prasad, A.; Gupta, S.C.; Niranjan, A.; Lehri, A.; Singh, S.S.; Misra, P.; Chakrabarty, D. Growth, Phytochemical and Gene Expression Changes Related to the Secondary Metabolite Synthesis of Solanum viarum Dunal. Ind. Crops Prod. 2021, 166, 113464. [Google Scholar] [CrossRef]
- Luciano Braguini, W.; Valendolf Pires, N.; Bianchin Alves, B. Phytochemical Analysis, Antioxidant Properties and Brine Shrimp Lethality of Unripe Fruits of Solanum viarum. J. Young Pharm. 2018, 10, 159–163. [Google Scholar] [CrossRef]
- Confortin, T.C.; Todero, I.; Luft, L.; Teixeira, A.L.; Mazutti, M.A.; Zabot, G.L.; Tres, M.V. Valorization of Solanum viarum Dunal by Extracting Bioactive Compounds from Roots and Fruits Using Ultrasound and Supercritical CO2. Braz. J. Chem. Eng. 2019, 36, 1689–1702. [Google Scholar] [CrossRef]
- Confortin, T.C.; Todero, I.; Luft, L.; Schmaltz, S.; Ferreira, D.F.; Barin, J.S.; Mazutti, M.A.; Zabot, G.L.; Tres, M.V. Extraction of Bioactive Compounds from Senecio brasiliensis Using Emergent Technologies. 3 Biotech 2021, 11, 284. [Google Scholar] [CrossRef] [PubMed]
- Cho, S.H.; Tóth, K.; Kim, D.; Vo, P.H.; Lin, C.H.; Handakumbura, P.P.; Ubach, A.R.; Evans, S.; Paša-Tolić, L.; Stacey, G. Activation of the Plant Mevalonate Pathway by Extracellular ATP. Nat. Commun. 2022, 13, 450. [Google Scholar] [CrossRef] [PubMed]
- Twaij, B.M.; Hasan, M.N. Bioactive Secondary Metabolites from Plant Sources: Types, Synthesis, and Their Therapeutic Uses. Int. J. Plant Biol. 2022, 13, 4–14. [Google Scholar] [CrossRef]
- dos Santos, M.S.N.; Wancura, J.H.C.; Oro, C.E.D.; Dallago, R.M.; Tres, M.V. Opportunities and Challenges of Plant Bioactive Compounds for Food and Agricultural-Related Areas. Phyton (B. Aires). 2022, 91, 1105–1127. [Google Scholar] [CrossRef]
- Pang, Z.; Chen, J.; Wang, T.; Gao, C.; Li, Z.; Guo, L.; Xu, J.; Cheng, Y. Linking Plant Secondary Metabolites and Plant Microbiomes: A Review. Front. Plant Sci. 2021, 12, 621276. [Google Scholar] [CrossRef] [PubMed]
- Sadeqifard, S.; Mirmostafaee, S.; Joharchi, M.R.; Zandavifard, J.; Azizi, M.; Fujii, Y. Evaluation of Allelopathic Activity Interactions of Some Medicinal Plants Using Fractional Inhibitory Concentration and Isobologram. Agronomy 2022, 12, 3001. [Google Scholar] [CrossRef]
- Soriano, G.; Petrillo, C.; Masi, M.; Bouafiane, M.; Khelil, A.; Tuzi, A.; Isticato, R.; Fernández-Aparicio, M.; Cimmino, A. Specialized Metabolites from the Allelopathic Plant Retama Raetam as Potential Biopesticides. Toxins 2022, 14, 311. [Google Scholar] [CrossRef] [PubMed]
- Hickman, D.T.; Rasmussen, A.; Ritz, K.; Birkett, M.A.; Neve, P. Review: Allelochemicals as Multi-Kingdom Plant Defence Compounds: Towards an Integrated Approach. Pest Manag. Sci. 2021, 77, 1121–1131. [Google Scholar] [CrossRef]
- Kim, H.W.; Choi, S.Y.; Jang, H.S.; Ryu, B.; Sung, S.H.; Yang, H. Exploring Novel Secondary Metabolites from Natural Products Using Pre-Processed Mass Spectral Data. Sci. Rep. 2019, 9, 17430. [Google Scholar] [CrossRef] [PubMed]
- Xu, D.; Xue, M.; Shen, Z.; Jia, X.; Hou, X.; Lai, D.; Zhou, L. Phytotoxic Secondary Metabolites from Fungi. Toxins 2021, 13, 261. [Google Scholar] [CrossRef] [PubMed]
- El Sawi, S.A.; Ibrahim, M.E.; El-Rokiek, K.G.; El-Din, S.A.S. Allelopathic Potential of Essential Oils Isolated from Peels of Three Citrus Species. Ann. Agric. Sci. 2019, 64, 89–94. [Google Scholar] [CrossRef]
- Carvalho, M.S.S.; Andrade-Vieira, L.F.; Santos, F.E.d.; Correa, F.F.; das Graças Cardoso, M.; Vilela, L.R. Allelopathic Potential and Phytochemical Screening of Ethanolic Extracts from Five Species of Amaranthus spp. in the Plant Model Lactuca Sativa. Sci. Hortic. 2019, 245, 90–98. [Google Scholar] [CrossRef]
- Zhao, W.; Zheng, Z.; Zhang, J.L.; Roger, S.F.; Luo, X.Z. Allelopathically Inhibitory Effects of Eucalyptus Extracts on the Growth of Microcystis aeruginosa. Chemosphere 2019, 225, 424–433. [Google Scholar] [CrossRef] [PubMed]
- Kueh, B.W.B.; Yusup, S.; Osman, N.; Ramli, N.H. Analysis of Melaleuca Cajuputi Extract as the Potential Herbicides for Paddy Weeds. Sustain. Chem. Pharm. 2019, 11, 36–40. [Google Scholar] [CrossRef]
- Arasu, M.V.; Viayaraghavan, P.; Ilavenil, S.; Al-Dhabi, N.A.; Choi, K.C. Essential Oil of Four Medicinal Plants and Protective Properties in Plum Fruits against the Spoilage Bacteria and Fungi. Ind. Crops Prod. 2019, 133, 54–62. [Google Scholar] [CrossRef]
- Ma, Y.N.; Xu, F.R.; Chen, C.J.; Li, Q.Q.; Wang, M.Z.; Cheng, Y.X.; Dong, X. The Beneficial Use of Essential Oils from Buds and Fruit of Syzygium aromaticum to Combat Pathogenic Fungi of Panax Notoginseng. Ind. Crops Prod. 2019, 133, 185–192. [Google Scholar] [CrossRef]
- Balouiri, M.; Sadiki, M.; Ibnsouda, S.K. Methods for in Vitro Evaluating Antimicrobial Activity: A Review. J. Pharm. Anal. 2016, 6, 71–79. [Google Scholar] [CrossRef] [PubMed]
- Zabka, M.; Pavela, R.; Gabrielova-Slezakova, L. Promising Antifungal Effect of Some Euro-Asiatic Plants against Dangerous Pathogenic and Toxinogenic Fungi. J. Sci. Food Agric. 2011, 91, 492–497. [Google Scholar] [CrossRef] [PubMed]
- Brazilian Ministry of Agriculture Livestock and Supply. Rule for Seed Analysis; Brazilian Ministry of Agriculture Livestock and Supply: Brasília, Brazil, 2009. [Google Scholar]
- Weisany, W.; Samadi, S.; Amini, J.; Hossaini, S.; Yousefi, S.; Maggi, F. Enhancement of the Antifungal Activity of Thyme and Dill Essential Oils against Colletotrichum nymphaeae by Nano-Encapsulation with Copper NPs. Ind. Crops Prod. 2019, 132, 213–225. [Google Scholar] [CrossRef]
- Salem, M.Z.M.; Behiry, S.I.; EL-Hefny, M. Inhibition of Fusarium culmorum, Penicillium chrysogenum and Rhizoctonia solani by n-Hexane Extracts of Three Plant Species as a Wood-Treated Oil Fungicide. J. Appl. Microbiol. 2019, 126, 1683–1699. [Google Scholar] [CrossRef] [PubMed]
- Sollepura Boregowda, R.; Murali, N.; Udayashankar, A.C.; Niranjana, S.R.; Lund, O.S.; Prakash, H.S. Antifungal Activity of Eclipta alba Metabolites against Sorghum Pathogens. Plants 2019, 8, 72. [Google Scholar] [CrossRef]
- Seepe, H.A.; Lodama, K.E.; Sutherland, R.; Nxumalo, W.; Amoo, S.O. In Vivo Antifungal Activity of South African Medicinal Plant Extracts against Fusarium Pathogens and Their Phytotoxicity Evaluation. Plants 2020, 9, 1668. [Google Scholar] [CrossRef] [PubMed]
- Hernández-Ceja, A.; Loeza-Lara, P.D.; Espinosa-García, F.J.; García-Rodríguez, Y.M.; Medina-Medrano, J.R.; Gutiérrez-Hernández, G.F.; Ceja-Torres, L.F. In Vitro Antifungal Activity of Plant Extracts on Pathogenic Fungi of Blueberry (Vaccinium sp.). Plants 2021, 10, 852. [Google Scholar] [CrossRef] [PubMed]
- Galvez, C.E.; Jimenez, C.M.; Gomez, A.d.l.A.; Lizarraga, E.F.; Sampietro, D.A. Chemical Composition and Antifungal Activity of Essential Oils from Senecio nutans, Senecio viridis, Tagetes terniflora and Aloysia gratissima against Toxigenic Aspergillus and Fusarium Species. Nat. Prod. Res. 2020, 34, 1442–1445. [Google Scholar] [CrossRef]
- Singh, R.; Ahluwalia, V.; Singh, P.; Kumar, N.; Prakash Sati, O.; Sati, N. Antifungal and Phytotoxic Activity of Essential Oil from Root of Senecio amplexicaulis Kunth. (Asteraceae) Growing Wild in High Altitude-Himalayan Region. Nat. Prod. Res. 2016, 30, 1875–1879. [Google Scholar] [CrossRef]
- Elhidar, N.; Nafis, A.; Kasrati, A.; Goehler, A.; Bohnert, J.A.; Abbad, A.; Hassani, L.; Mezrioui, N.-E. Chemical Composition, Antimicrobial Activities and Synergistic Effects of Essential Oil from Senecio anteuphorbium, a Moroccan Endemic Plant. Ind. Crops Prod. 2019, 130, 310–315. [Google Scholar] [CrossRef]
- Basaid, K.; Mayad, E.H.; Bouharroud, R.; Furze, J.N.; Benjlil, H.; de Oliveira, A.L.; Chebli, B. Biopesticidal Value of Senecio glaucus Subsp. Coronopifolius Essential Oil against Pathogenic Fungi, Nematodes, and Mites. Mater. Today Proc. 2020, 27, 3082–3090. [Google Scholar] [CrossRef]
- Ajaib, M.; Kamran, S.H.; Siddiqui, M.F.; Qasim, M.; Azeem, M.; Abideen, Z.; Elnaggar, A.; El-Keblawy, A. Exploring the Phytochemical, Antioxidant, Antimicrobial and Analgesic Potentials of Solanum Erianthum as an Alternative Biological Feedstock for Producing Sustainable Biochemicals. Biocatal. Agric. Biotechnol. 2024, 58, 103183. [Google Scholar] [CrossRef]
- Senizza, B.; Rocchetti, G.; Sinan, K.I.; Zengin, G.; Mahomoodally, M.F.; Glamocilja, J.; Sokovic, M.; Lobine, D.; Etienne, O.K.; Lucini, L. The Phenolic and Alkaloid Profiles of Solanum erianthum and Solanum torvum Modulated Their Biological Properties. Food Biosci. 2021, 41, 100974. [Google Scholar] [CrossRef]
- Cabanillas, B.; Chassagne, F.; Vásquez-Ocmín, P.; Tahrioui, A.; Chevalier, S.; Vansteelandt, M.; Triastuti, A.; Amasifuen Guerra, C.A.; Fabre, N.; Haddad, M. Pharmacological Validation of Solanum mammosum L. as an Anti-Infective Agent: Role of Solamargine. J. Ethnopharmacol. 2021, 280, 114473. [Google Scholar] [CrossRef] [PubMed]
- Pinto, F.d.C.L.; Uchoa, D.E.d.A.; Silveira, E.R.; Pessoa, O.D.L.; Braz-Filho, R.; e Silva, F.M.; Theodoro, P.N.E.T.; Espíndola, L.S. Antifungal Glycoalkaloids, Flavonoids and Other Chemical Constituents of Solanum asperum Rich (Solanaceae). Quim. Nova 2011, 34, 284–288. [Google Scholar] [CrossRef]
- Rocheleau, H.; Al-harthi, R.; Ouellet, T. Degradation of Salicylic Acid by Fusarium graminearum. Fungal Biol. 2019, 123, 77–86. [Google Scholar] [CrossRef]
- Shao, J.; Pei, Z.; Jing, H.; Wang, L.; Jiang, C.; Du, X.; Jiang, C.; Lou, Z.; Wang, H. Antifungal Activity of Myriocin against Fusarium graminearum and Its Inhibitory Effect on Deoxynivalenol Production in Wheat Grains. Physiol. Mol. Plant Pathol. 2021, 114, 101635. [Google Scholar] [CrossRef]
- Willbur, J.F.; Fall, M.L.; Bloomingdale, C.; Byrne, A.M.; Chapman, S.A.; Isard, S.A.; Magarey, R.D.; McCaghey, M.M.; Mueller, B.D.; Russo, J.M.; et al. Weather-Based Models for Assessing the Risk of Sclerotinia Sclerotiorum Apothecial Presence in Soybean (Glycine Max) Fields. Plant Dis. 2018, 102, 73–84. [Google Scholar] [CrossRef]
- Alves, N.M.; Guimarães, R.A.; Guimarães, S.S.C.; Faria, A.F.; Santos, Í.A.F.M.; de Medeiros, F.H.V.; Jank, L.; Cardoso, P.G. A Trojan Horse Approach for White Mold Biocontrol: Paraconiothyrium Endophytes Promotes Grass Growth and Inhibits Sclerotinia sclerotiorum. Biol. Control 2021, 160, 104685. [Google Scholar] [CrossRef]
- Grande-pérez, A.; Martín, S.; Cuevas, J.M.; Elena, S.F. Putative Antiviral Role of Plant Cytidine Deaminases. F1000Research 2017, 6, 1–14. [Google Scholar] [CrossRef]
- Walters, D.; Raynor, L.; Mitchell, A.; Walker, R.; Walker, K. Antifungal Activities of Four Fatty Acids against Plant Pathogenic Fungi. Mycopathologia 2004, 157, 87–90. [Google Scholar] [CrossRef] [PubMed]
- Hugar, A.L.; Londonkar, R.L. GC-MS Profiling of Bioactive Components from Aqueous Extract of Pterocarpus marsupium. Int. J. ChemTech Res. 2017; 10, 557–564. [Google Scholar]
- Casuga, F.P.; Castillo, A.L.; Corpuz, M.J.A.T. GC–MS Analysis of Bioactive Compounds Present in Different Extracts of an Endemic Plant Broussonetia luzonica (Blanco) (Moraceae) Leaves. Asian Pac. J. Trop. Biomed. 2016, 6, 957–961. [Google Scholar] [CrossRef]
- Foo, L.W.; Salleh, E.; Nur, S.; Mamat, H. P-53:Extraction and Qualitative Analysis of Piper Betle Leaves for Antimicrobial Activities. Int. J. Eng. Technol. Sci. Res. 2015, 2, 1–8. [Google Scholar]
- Abubacker, M.N.; Devi, P.K. In Vitro Antifungal Potentials of Bioactive Compounds Heptadecane, 9- Hexyl and Ethyl Iso-Allocholate Isolated from Lepidagathis cristata Willd. (Acanthaceae) Leaf. Br. Biomed. Bull. 2015, 3, 336–343. [Google Scholar]
- Santos, K.A.; Klein, E.J.; da Silva, C.; da Silva, E.A.; Cardozo-Filho, L. Extraction of Vetiver (Chrysopogon zizanioides) Root Oil by Supercritical CO2, Pressurized-Liquid, and Ultrasound-Assisted Methods and Modeling of Supercritical Extraction Kinetics. J. Supercrit. Fluids 2019, 150, 30–39. [Google Scholar] [CrossRef]
- Piochon, M.; Legault, J.; Gauthier, C.; Pichette, A. Phytochemistry Synthesis and Cytotoxicity Evaluation of Natural α-Bisabolol β-D-Fucopyranoside and Analogues. Phytochemistry 2009, 70, 228–236. [Google Scholar] [CrossRef] [PubMed]
- Pauli, A. α-Bisabolol from Chamomile—A Specific Ergosterol Biosynthesis Inhibitor? Int. J. Aromather. 2006; 16, 21–25. [Google Scholar] [CrossRef]
- Fraga, B.M.; González-Coloma, A.; Alegre-Gómez, S.; López-Rodríguez, M.; Amador, L.J.; Díaz, C.E. Bioactive Constituents from Transformed Root Cultures of Nepeta teydea. Phytochemistry 2017, 133, 59–68. [Google Scholar] [CrossRef] [PubMed]
- Chattapadhyay, T.K.; Dureja, P. Antifungal Activity of 4-Methyl-6-Alkyl-2H-Pyran-2-Ones. J. Agric. Food Chem. 2006, 54, 2129–2133. [Google Scholar] [CrossRef] [PubMed]
- Scognamiglio, M. Identification of Potential Allelochemicals from Donor Plants and Their Synergistic Effects on the Metabolome of Aegilops geniculata. Front. Plant Sci. 2020, 11, 535128. [Google Scholar] [CrossRef] [PubMed]
- Pardo-Muras, M.; Puig, C.G.; Pedrol, N. Complex Synergistic Interactions among Volatile and Phenolic Compounds Underlie the Effectiveness of Allelopathic Residues Added to the Soil for Weed Control. Plants 2022, 11, 1114. [Google Scholar] [CrossRef] [PubMed]
- Todero, I.; Confortin, T.C.; Luft, L.; Brun, T.; Ugalde, G.A.; de Almeida, T.C.; Arnemann, J.A.; Zabot, G.L.; Mazutti, M.A. Formulation of a Bioherbicide with Metabolites from Phoma sp. Sci. Hortic. 2018, 241, 285–292. [Google Scholar] [CrossRef]
- Chaves Neto, J.R.; Luft, L.; Confortin, T.C.; Todero, I.; Mazutti, M.A.; Zabot, G.L.; Tres, M.V. Efeito de Metabólitos Secundários Produzidos Por Phoma Dimorpha Sobre a Germinação e Crescimento de Sementes de Diferentes Espécies Vegetais. Acta Iguazu 2020, 9, 109–121. [Google Scholar] [CrossRef]
- Cao, G.; Wang, M.; Wang, M.; Wang, S.; Li, Y.; Li, Z. Synthesis and Herbicidal Activity of Novel Sulfonylurea Derivatives. Chem. Res. Chin. Univ. 2011, 27, 60–65. [Google Scholar] [CrossRef] [PubMed]
- Yuan, B.; Byrnes, D.; Giurleo, D.; Villani, T.; Simon, J.E.; Wu, Q. ScienceDirect Rapid Screening of Toxic Glycoalkaloids and Micronutrients in Edible Nightshades (Solanum Spp.). J. Food Drug Anal. 2017, 26, 751–760. [Google Scholar] [CrossRef] [PubMed]
- Kausar, M.; Singh, B.K. Pharmacological Evaluation of Solanum viarum Dunal Leaves Extract for Analgesic and Antipyretic Activities. J. Drug Deliv. Ther. 2018, 8, 356–361. [Google Scholar] [CrossRef]
- Wang, L.; Weller, C.L. Recent Advances in Extraction of Nutraceuticals from Plants. Trends Food Sci. Technol. 2006, 17, 300–312. [Google Scholar] [CrossRef]
- Gallo, M.; Formato, A.; Ianniello, D.; Andolfi, A.; Conte, E.; Ciaravolo, M.; Varchetta, V.; Naviglio, D. Supercritical Fluid Extraction of Pyrethrins from Pyrethrum Flowers (Chrysanthemum cinerariifolium) Compared to Traditional Maceration and Cyclic Pressurization Extraction. J. Supercrit. Fluids 2017, 119, 104–112. [Google Scholar] [CrossRef]
- Chen, M.; Du, Y.; Zhu, G.; Takamatsu, G.; Ihara, M.; Matsuda, K.; Zhorov, B.S.; Dong, K. Action of Six Pyrethrins Purified from the Botanical Insecticide Pyrethrum on Cockroach Sodium Channels Expressed in Xenopus oocytes. Pestic. Biochem. Physiol. 2018, 151, 82–89. [Google Scholar] [CrossRef] [PubMed]
- Bülent Köse, Y.; Iscan, G.; Demirci, B. Antimicrobial Activity of the Essential Oils Obtained from Flowering Aerial Parts of Centaurea Lycopifolia Boiss. et Kotschy and Centaurea Cheirolopha (Fenzl) Wagenitz from Turkey. J. Essent. Oil-Bear. Plants 2016, 19, 762–768. [Google Scholar] [CrossRef]
- Zakaria, M.B.; Vijayasekaran; Ilham, Z.; Muhamad, N.A. Anti-Inflammatory Activity of Calophyllum inophyllum Fruits Extracts. Procedia Chem. 2014, 13, 218–220. [Google Scholar] [CrossRef]
- De Souza, R.R.; Bretanha, L.C.; Dalmarco, E.M.; Pizzolatti, M.G.; Fröde, T.S. Modulatory Effect of Senecio brasiliensis (Spreng) Less. in a Murine Model of Inflammation Induced by Carrageenan into the Pleural Cavity. J. Ethnopharmacol. 2015, 168, 373–379. [Google Scholar] [CrossRef] [PubMed]
- Radhakrishnan, R.; Alqarawi, A.A.; Abd Allah, E.F. Bioherbicides: Current Knowledge on Weed Control Mechanism. Ecotoxicol. Environ. Saf. 2018, 158, 131–138. [Google Scholar] [CrossRef] [PubMed]
- Hussain, I.; Singh, N.B.; Singh, A.; Singh, H. Allelopathic Potential of Sesame Plant Leachate against Cyperus rotundus L. Ann. Agrar. Sci. 2017, 15, 141–147. [Google Scholar] [CrossRef]
- Scavo, A.; Restuccia, A.; Pandino, G.; Onofri, A.; Mauromicale, G. Allelopathic Effects of Cynara cardunculus L. Leaf Aqueous Extracts on Seed Germination of Some Mediterranean Weed Species. Ital. J. Agron. 2018, 13, 119–125. [Google Scholar] [CrossRef]
- Scavo, A.; Pandino, G.; Restuccia, A.; Mauromicale, G. Leaf Extracts of Cultivated Cardoon as Potential Bioherbicide. Sci. Hortic. 2020, 261, 109024. [Google Scholar] [CrossRef]
- Kaab, S.B.; Rebey, I.B.; Hanafi, M.; Hammi, K.M.; Smaoui, A.; Fauconnier, M.L.; De Clerck, C.; Jijakli, M.H.; Ksouri, R. Screening of Tunisian Plant Extracts for Herbicidal Activity and Formulation of a Bioherbicide Based on Cynara cardunculus. South Afr. J. Bot. 2020, 128, 67–76. [Google Scholar] [CrossRef]
- Ahmad, H.; Ali, N.; Ahmad, B.; Khan, I. Screening of Solanum surrattense for Antibacterial, Antifungal, Phytotoxic and Haemagglutination. J. Tradit. Chin. Med. 2012, 32, 616–620. [Google Scholar] [CrossRef] [PubMed]
- Balah, M.A.; AbdelRazek, G.M. Pesticidal Activity of Solanum elaeagnifolium Cav. Leaves against Nematodes and Perennial Weeds. Acta Ecol. Sin. 2020, 40, 373–379. [Google Scholar] [CrossRef]

| Botanical Part | Yield (wt.%) | Compounds with Biological Activity 1 |
|---|---|---|
| S. viarum | ||
| Salsodine | ||
| Cydine | ||
| Fruit | 19.15 | Quinic acid |
| Root | 10.20 | Piperazine |
| Mannofuranoside | ||
| 1,8 Diazabicyclo [5.4.0] undec-7-ene | ||
| S. brasiliensis | ||
| Integerrimine | ||
| Senecionine | ||
| Propanetriol | ||
| Cinerin | ||
| Leaf | 10.68 | Celidoniol |
| Flower | 6.52 | Hexadecanoic acid |
| Stalk | 5.57 | Phenol |
| Octadecenoic acid | ||
| 2-Methoxy-4-vinyl phenol | ||
| Guanosine | ||
| 5H-1-Pyridinol |
| IP (%) | |||||
|---|---|---|---|---|---|
| S. brasiliensis | S. viarum | ||||
| Flowers | Leaves | Stalks | Fruits | Roots | |
| F. graminearum | 60.18 ± 0.14 bG | 75.02 ± 0.17 aD | 58.75 ± <0.1 cH | 62.02 ± 0.11 bF | 65.01 ± 0.15 aE |
| S. sclerotiorum | 74.27 ± 0.10 cG | 82.01 ± 0.31 aD | 77.65 ± 0.24 bF | 77.05 ± 0.15 bF | 81.15 ± 0.12 aE |
| GI (%) 1 | |||||
|---|---|---|---|---|---|
| S. brasiliensis | S. viarum | ||||
| Flowers | Leaves | Stalks | Fruits | Roots | |
| C. sativus | 100 ± 0.14 aA | 100 ± 0.17 aA | 100 ± <0.01 aA | 100 ± 0.11 aA | 100 ± 0.15 aA |
Disclaimer/Publisher’s Note: The statements, opinions and data contained in all publications are solely those of the individual author(s) and contributor(s) and not of MDPI and/or the editor(s). MDPI and/or the editor(s) disclaim responsibility for any injury to people or property resulting from any ideas, methods, instructions or products referred to in the content. |
© 2024 by the authors. Licensee MDPI, Basel, Switzerland. This article is an open access article distributed under the terms and conditions of the Creative Commons Attribution (CC BY) license (https://creativecommons.org/licenses/by/4.0/).
Share and Cite
Confortin, T.C.; Todero, I.; Luft, L.; Schmaltz, S.; Wancura, J.H.C.; dos Santos, M.S.N.; Brun, T.; Mazutti, M.A.; Zabot, G.L.; Draszewski, C.P.; et al. Extracts of Senecio brasiliensis and Solanum viarum as Potential Antifungal and Bioherbicidal Agents. Processes 2024, 12, 1208. https://doi.org/10.3390/pr12061208
Confortin TC, Todero I, Luft L, Schmaltz S, Wancura JHC, dos Santos MSN, Brun T, Mazutti MA, Zabot GL, Draszewski CP, et al. Extracts of Senecio brasiliensis and Solanum viarum as Potential Antifungal and Bioherbicidal Agents. Processes. 2024; 12(6):1208. https://doi.org/10.3390/pr12061208
Chicago/Turabian StyleConfortin, Tassia C., Izelmar Todero, Luciana Luft, Silvana Schmaltz, João H. C. Wancura, Maicon S. N. dos Santos, Thiarles Brun, Marcio A. Mazutti, Giovani L. Zabot, Crisleine P. Draszewski, and et al. 2024. "Extracts of Senecio brasiliensis and Solanum viarum as Potential Antifungal and Bioherbicidal Agents" Processes 12, no. 6: 1208. https://doi.org/10.3390/pr12061208
APA StyleConfortin, T. C., Todero, I., Luft, L., Schmaltz, S., Wancura, J. H. C., dos Santos, M. S. N., Brun, T., Mazutti, M. A., Zabot, G. L., Draszewski, C. P., Abaide, E. R., & Tres, M. V. (2024). Extracts of Senecio brasiliensis and Solanum viarum as Potential Antifungal and Bioherbicidal Agents. Processes, 12(6), 1208. https://doi.org/10.3390/pr12061208

